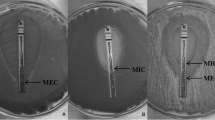

Abstract
Aspergillus species can cause ocular morbidity and blindness, and thus, appropriate antifungal therapy is needed. We investigated the in vitro activity of itraconazole, voriconazole, posaconazole, caspofungin, anidulafungin, and amphotericin B against 14 Aspergillus isolates obtained from patients with ocular mycoses, using the CLSI reference broth microdilution methodology. In addition, time-kill assays were performed, exposing each isolate separately to 1-, 4-, and 16-fold concentrations above the minimum inhibitory concentration (MIC) of each antifungal agent. A sigmoid maximum-effect (E max) model was used to fit the time-kill curve data. The drug effect was further evaluated by measuring an increase/decrease in the killing rate of the tested isolates. The MICs of amphotericin B, itraconazole, voriconazole, and posaconazole were 0.5–1.0, 1.0, 0.5–1.0, and 0.25 µg/ml for A. brasiliensis, A. niger, and A. tubingensis isolates, respectively, and 2.0–4.0, 0.5, 1.0 for A. flavus, and 0.12–0.25 µg/ml for A. nomius isolates, respectively. A. calidoustus had the highest MIC range for the azoles (4.0–16.0 µg/ml) among all isolates tested. The minimum effective concentrations of caspofungin and anidulafungin were ≤0.03–0.5 µg/ml and ≤0.03 µg/ml for all isolates, respectively. Posaconazole demonstrated maximal killing rates (E max = 0.63 h−1, r 2 = 0.71) against 14 ocular Aspergillus isolates, followed by amphotericin B (E max = 0.39 h−1, r 2 = 0.87), voriconazole (E max = 0.35 h−1, r 2 = 0.098), and itraconazole (E max = 0.01 h−1, r 2 = 0.98). Overall, the antifungal susceptibility of the non-fumigatus Aspergillus isolates tested was species and antifungal agent dependent. Analysis of the kinetic growth assays, along with consideration of the killing rates, revealed that posaconazole was the most effective antifungal against all of the isolates.
Similar content being viewed by others
Introduction
Fungal infections of the eye are still an important cause of ocular morbidity, particularly in developing countries [1]. Ocular mycoses are difficult to treat successfully because many fungal genera and species have been implicated in ocular infections. Notably, it is difficult to choose an appropriate treatment empirically because drugs are typically selected without considering the susceptibility data [2, 3]. Moreover, surgical intervention such as penetrating keratoplasty may be required for severe mycotic keratitis that cannot be treated because of the prognosis of empty lacunae, indicating bone necrosis [4, 5]. Thus, effective treatment with available antifungal agents is important to improve the outcome of ocular mycoses, and therefore, susceptibility testing may help to guide therapeutic decisions if performed in a timely manner.
In general, polyenes are effective against both filamentous and yeast forms of fungi. Natamycin is the only commercially available topical ophthalmic antifungal agent with a broad spectrum of activity against filamentous organisms, particularly for infections caused by Fusarium. However, because of poor ocular penetration, it has primarily been useful in cases with superficial corneal infection. In addition, topical amphotericin B is the drug of choice to treat patients with mycotic keratitis caused by yeasts [6].
Topical 1 % voriconazole has been found to be safe and effective for the primary management of mycotic keratitis, with an efficacy matching that of conventional natamycin [7]. In addition, Matsumoto et al. [8] showed that topical 0.1 % micafungin eyedrops are comparable to azoles in the treatment of mycotic keratitis, regardless of the patient’s age, sex, or ulcer size. Various fungal genera, including Fusarium, Aspergillus, Candida, Curvularia, Scedosporium spp., and Schizophyllum commune, frequently infect ocular structures [9–11]. Although most of the Aspergillus ocular infections are caused by A. fumigatus, mycotic keratitis caused by non-fumigatus Aspergillus species has increased significantly over the past few years [4]. In a study focusing on the Aspergillus genus as a causative agent of mycotic keratitis, A. flavus was found to be the predominant species (75 %), followed by A. fumigatus and A. terreus, as determined by molecular identification [12]. In addition, recent molecular studies revealed that the spectrum of Aspergillus species causing mycotic keratitis is much broader than previously believed and includes A. pseudotamarii, A. tamarii, A. nomius, A. tubingensis, and A. brasiliensis [13–17].
In the present study, we investigated the in vitro activity of itraconazole, voriconazole, posaconazole, caspofungin, anidulafungin, and amphotericin B against Aspergillus species isolated from the infected eyes of different patients throughout the world. The microdilution susceptibility test was performed according to the guidelines of the Clinical and Laboratory Standards Institute (CLSI) [18]. In addition, a microbroth kinetic growth assay was performed to generate basic pharmacodynamic information on the relationship between the various concentrations of the antifungals and the killing rate of each isolate, according to a maximum-effect (E max) model, as described previously [19, 20].
Materials and Methods
Aspergillus Isolates
In total, 14 isolates from different clinical sources were obtained from the reference culture collection of the CBS-KNAW Fungal Biodiversity Centre, Utrecht, the Netherlands. Table 1 shows the origin, identification number, and clinical data of each isolate used in the current study.
Antifungal Drugs
Itraconazole (Janssen, Beerse, Belgium), voriconazole (Pfizer, New York, NY, USA), posaconazole (Schering-Plough, Kenilworth, NJ, USA), caspofungin (Merck, Rahway, NJ, USA), anidulafungin (Pfizer, New York, NY, USA), and amphotericin B (Sigma, St. Louis, MO, USA) were obtained as standard powders from their manufacturers. Antifungal stock solutions were prepared in dimethyl sulfoxide (for itraconazole, voriconazole, posaconazole, anidulafungin, and amphotericin B) or distilled water (for caspofungin). The drug dilutions were prepared in RPMI 1640 medium (Sigma-Aldrich, Steinheim, Germany) buffered to pH 7.0 with 0.165 M MOPS (morpholinopropanesulfonic acid; Sigma-Aldrich, Steinheim, Germany). In vitro antifungal susceptibility testing was performed with the six antifungal compounds using a broth microdilution format according to the CLSI guidelines [18], utilizing an XTT dye [19, 21]. The final concentrations of amphotericin B (AMB), itraconazole (ITC), voriconazole (VRC), posaconazole (POS), caspofungin (CAS), and anidulafungin (AFG) ranged from 0.0313 to 16 µg/ml. The solutions were dispensed into 96-well microtiter plates and stored at −70 °C until use. The results were read using a reading mirror and a microtitration plate spectrophotometric reader (BIO-TEK, ELX800, USA).
Antifungal Susceptibility Testing
Each isolate was subcultured on potato dextrose agar (Merck, Darmstadt, Germany) for 7 days at 35 °C to ensure its viability and purity. The fungal colonies were covered with 1 ml of sterile 0.85 % saline, and a suspension was prepared by gentle probing of the colonies. The resulting suspensions were withdrawn and transferred to a sterile tube where the heavy particles were allowed to settle for 3–5 min, and the upper homogeneous suspension was transferred to another sterile tube. The final fungal suspensions were adjusted to an optical density (OD) of 0.09–0.13 at 530 nm using a spectrophotometer. These suspensions were diluted 1:50 in RPMI 1640, and the final inoculum size was approximately 0.4–5 × 104 CFU/ml. The final inoculum size was also confirmed with a quantitative colony count on Sabouraud glucose agar (Merck, Darmstadt, Germany). Each well of the microtiter plates was inoculated with 0.1 ml of fungal suspension and incubated at 35 °C, and the minimal inhibitory concentrations (MICs) were determined at 48 h. Growth (drug-free) and sterilized (microorganism-free) control wells were included for each isolate, and all of the strains were evaluated twice for antifungal drug susceptibility.
The MIC endpoints for the azoles and AMB were defined as the lowest concentration that produced complete inhibition of growth. The minimum effective concentration (MEC) of CAS and AFG was defined as the lowest concentration at which the fungi display microscopic morphological changes [18].
The quality control strains Paecilomyces variotii (ATCC 22319), Candida parapsilosis (ATCC 22019), and Candida krusei (ATCC 6258) were used in all experiments. The ranges and the geometric means (GM) of the MIC and MEC were determined for each species and drug after 48 h of incubation. The MIC50 and MIC90 values were not calculated due to the limited number of species. If the MIC value of the replicates was different, the GM values of the replicates were used for comparison with other isolates. All experiments were performed in triplicate on different days.
XTT and Menadione
XTT (Sigma-Aldrich, St. Louis, MO, USA) was dissolved in saline at a concentration of 1 mg/ml, and after it was completely dissolved, the solution was filtered through a filter with a pore size of 0.22 µm. Menadione (Sigma-Aldrich, St. Louis, MO, USA) was first dissolved in acetone at a concentration of 10 mM and then diluted 1:10 in saline. The final solution of 1 mg/ml XTT with 125 µM menadione was prepared in saline [19, 21].
Colorimetric Microbroth Kinetic Growth Assay
Killing curves were obtained by following a procedure described previously [20, 22]. Briefly, concentrations 1-, 4-, and 16-fold higher than the determined MIC were calculated for each antifungal agent. Separate microplates were used for each time point of incubation (2, 6, 12, 24, and 48 h). The wells in the first column included 100 µl of media without drugs (growth control), and the wells in the fifth column included 200 µl of media without drugs and conidia (negative control) in each microplate, which were processed in the same manner as the inoculated wells. The next three columns were inoculated with 100 µl of three different concentrations of ITC, VRC, and AMB or CAS, AFG, and POS, with the ninth column left empty. The inoculum suspensions were prepared at a concentration of 1 × 106 to 5 × 106 conidia/ml and diluted 1:5 in RPMI 1640. The inoculum suspension (100 µl) was then inoculated into each well, and all plates were incubated at 37 °C for up to 48 h. Each plate was taken from the incubator 2 h prior to the end of the incubation time, and 50 µl of XTT–menadione solution was added to each well. After 2 h of incubation with XTT, the formazan absorbance for each well was read at 450 and 492 nm with a microplate reader. All experiments were performed in duplicate on two different days. The results were evaluated by comparing the absorbance in the growth with the negative control conditions.
Curve Fitting and Analysis
The experimental data derived from the colorimetric growth assays were analyzed using GraphPad Prism 5.3 (GraphPad Inc., San Diego, CA, USA) as described previously [22–24]. Log-transformed optical densities were plotted against time for each antifungal agent. The kill rate was determined at time intervals of 2–48 h for the azoles and AMB and 2–24 h for the echinocandins via a linear regression analysis. The log-transformed concentrations were then plotted against the slopes obtained from the linear regression analysis of the log-transformed optical densities versus time for each antifungal agent against the 14 tested isolates. The sigmoid maximum-effect (E max: model four-parameter Hill’s equation) model was used to fit the kill rate data to determine the pharmacodynamic relationship between the antifungal concentration and fungal growth or death. E max, the 50 % effective concentration (EC50), was calculated for each assay. The goodness of fit for the E max model was checked by R 2 and visual inspection. The P value of <0.05 (two tailed) was considered for statistical significance.
Results
The antifungal susceptibility test results for all isolates are presented in Table 2. Overall, our results indicated that MIC and MEC endpoints determined by either visual or spectrophotometric readings were similar. The MIC values of AMB were from 0.5 to 4.0 µg/ml, and the lowest MIC values were for A. brasiliensis and A. niger isolates, whereas the highest MIC value was for the A. flavus isolate.
ITC MIC values were 0.25 µg/ml for A. tamarii, 4.0 µg/ml for A. calidoustus isolates, and 0.5–1 µg/ml for the other isolates. The MIC values of VRC were 0.5–1 µg/ml for all isolates except for A. calidoustus, which had the highest MIC range for azoles (4.0–16.0 µg/ml) among all of the isolates tested. The lowest azole MICs were observed with POS; except for A. calidoustus, all MIC values of POS were 0.12–0.25 µg/ml. The MEC values of echinocandins were very low; all AFG MECs were ≤0.03 µg/ml, and the CAS MECs were ≤0.03–0.5 µg/ml. In addition, the MIC/MEC values of the drugs tested on the quality control isolates were in acceptable ranges (Table 2).
Figure 1 shows the relationship between the kill rate and the concentration for all Aspergillus species evaluated. The E max model was a good fit for the kill rate data. Posaconazole had the maximal killing rates (E max = 0.63 h−1, r 2 = 0.71) against the 14 ocular Aspergillus isolates, followed by amphotericin B (E max = 0.39 h−1, r 2 = 0.87), voriconazole (E max = 0.35 h−1, r 2 = 0.098), and itraconazole (E max = 0.01 h−1, r 2 = 0.98), indicating that posaconazole was the most effective antifungal agent against all of the isolates tested. However, it was not possible to determine the maximal and half-maximum killing rates for CAS and AFG against any of the non-fumigatus Aspergillus species tested.
Best-fit sigmoid curves obtained from the E max model of non-fumigatus Aspergillus species exposed to various antifungals. Posaconazole had the highest E max (0.63 h−1, r 2 = 0.71), followed by amphotericin B (0.39 h−1, r 2 = 0.87), voriconazole (0.35 h−1, r 2 = 0.098), and itraconazole (0.01 h−1, r 2 = 0.98). The kill rate was determined at time intervals of 2–48 h via a linear regression analysis. The sigmoid maximum-effect model was then used to fit the time-kill curve data. The symbols shown represent slopes obtained from linear regression analysis of log-transformed optical densities versus time for each antifungal agent against 14 isolates
Discussion
Ocular mycoses are serious infections of the cornea, orbit, and other ocular structures that may result in blindness or reduced vision [11]. Successful therapy for ocular mycoses relies on identification of the causal agents at the species level and antifungal susceptibility testing. Importantly, the in vitro susceptibility testing of fungi isolated from ophthalmic lesions is considered to guide the clinician in the selection of an appropriate antifungal compound [4].
The pattern of growth and killing rates of all isolates were further investigated by a microbroth kinetic growth assay. Both azoles and AMB were the most potent antifungal agents against all isolates tested; in contrast, echinocandins did not completely inhibit the growth of any of the tested isolates in a concentration-dependent manner.
Recent revisions of the taxonomy of Aspergillus spp. have had major implications for the understanding of drug susceptibility profiles [23]. New sibling species of A. fumigatus exhibit in vitro susceptibility profiles that differ significantly from that of A. fumigatus. Whereas acquired azole resistance is an emerging problem for A. fumigatus [24, 25], other Aspergillus spp. may be intrinsically resistant to specific classes of antifungal agents (Table 2). The MIC of AMB and azoles for some of the non-fumigatus Aspergillus spp. was elevated compared with those for A. fumigatus [23]. The MIC of AMB in A. flavus clinical isolates was consistently two-fold higher than that in A. fumigatus [26]. Using CLSI, AMB was shown to have MIC values of 1–2 mg/l in A. nidulans, which was higher than the values commonly observed with A. fumigatus [27]. In the section Usti, the azoles were not active against A. calidoustus, with MICs of ≥8 mg/l, and the other classes of antifungal drugs also appeared to be less active compared with their activity against A. fumigatus. For instance, the MICs of AMB were shown to be 1–2 mg/l, which is relatively high [28]. The resistance of A. terreus to amphotericin B is well recognized [29]. Based on azole susceptibility, three different susceptibility patterns were distinguished in the black aspergilla, Aspergillus, section Nigri. Azoles showed low MICs in some isolates and high MICs in other isolates; a third group of isolates showed an uncommon paradoxical effect. However, these groups did not coincide with species boundaries, making it difficult to interpret the difference in MIC as an intrinsic or acquired property of these molds [30, 31].
In general, voriconazole is the recommended first-choice drug for the prophylaxis and management of mycotic endophthalmitis and keratitis against filamentous organisms [32, 33]. However, new-generation triazoles such as posaconazole have shown good safety profiles in both laboratory and clinical studies [34]. In the current study, we also found that posaconazole had a lower MIC than voriconazole against all non-fumigatus Aspergillus species except A. calidoustus isolates, which had the highest MIC values (≥4.0 µg/ml) against all azoles.
The growth and kill curves of POS did not show apparent inhibition, while ITC and VRC exhibited persistent inhibition against A. calidoustus isolates at concentrations equal to or higher than the MIC. This newly described isolate is considered to be a relatively rare human pathogen but appears to represent an emerging problem, as A. calidoustus isolates have been found to be triazole resistant in several recent studies [28, 35–37]. Although our findings reaffirm the elevated triazole MIC for A. calidoustus isolates, the POS resistance was more evident when using the time-kill method with the XTT colorimetric assay in our in vitro study. ITC and VRC exhibited prominent inhibition at concentrations equal to or higher than the MIC, even though the MIC was elevated. In this scenario, topical usage of ITC and VRC at higher doses may be promising for treatment of ocular infections caused by A. calidoustus. However, variation in the activity of the itraconazole should be considered depending on the type of Aspergillus species. In studies reported by an Indo-Hungarian group, itraconazole showed a higher in vitro MIC in A. tubingensis isolates obtained from mycotic keratitis [12, 16].
CAS and AFG had the lowest MEC values against all of the Aspergillus isolates tested; however, they did not exhibit concentration-dependent inhibition of fungal growth in the time-kill assay, possibly because of the heterogeneous growth characteristics of Aspergillus spp. [21] and the paradoxical effects of echinocandins [38]. In several recent in vitro studies incorporating ocular isolates, CAS and AFG presented excellent activity against various Aspergillus species in the broth microdilution method, in which the MEC values were low (≤0.008–1 µg/ml for CAS and ≤0.001–0.015 µg/ml for AFG) [2, 39–42]. Similar to our study, Lockhart et al. determined the echinocandin MEC values for caspofungin, micafungin, and anidulafungin against 288 Aspergillus isolates prospectively collected from transplant patients [43]. The MEC ranges for A. flavus, A. niger, A. calidoustus, and A. tubingensis were, respectively: 0.008–0.03 µg/ml for CAS and 0.008–0.015 µg/ml for AFG, 0.015–0.5 µg/ml for CAS and 0.008–0.03 µg/ml for AFG, 0.03–4 µg/ml for CAS and 0.008–0.06 µg/ml for AFG, and 0.015–0.03 µg/ml for CAS and 0.008 µg/ml for AFG [43].
In comparison with the other antifungal agents tested, we observed that the MIC of AMB tended to be higher against various Aspergillus species, which is similar to the findings reported in other studies including both ocular [2, 11, 44] and non-ocular isolates [28, 35, 42], with MIC values of ≤4 µg/ml. In our study, the time-killing assay of AMB demonstrated complete concentration-dependent inhibition of the growth of all isolates.
Of note, as discussed above, the results of the time-kill studies performed in the current study provided a more dynamic assessment of the interaction between the antifungals and the fungi isolated from ocular lesions than the static MIC determinations did. This indicates that the time-kill assay may have a greater clinical utility for guiding therapy in an individual patient. However, it should be noted that in the clinical setting, standardized in vitro MIC studies are easier to perform than monitoring of fungal growth in the time-kill kinetic system.
Furthermore, for an adequate therapeutic response, in addition to choosing an antifungal drug with a high level of activity against the etiological ocular pathogen, the drug must be non-irritating and non-toxic to the eye and penetrate well through the corneal layers [45]. Depending on the etiologic agent and the location and extent of the infection in the eye, various antifungal agents and several routes of administration, including intravenous, oral, topical, subconjunctival, intrastromal, intracameral, and intravitreal, should be considered [33]. Natamycin is the only commercially available topical antifungal agent approved by the US Food and Drug Administration (FDA) for ophthalmic use [33, 46]. Alternatively, topical administration of econazole, voriconazole, and posaconazole is recommended for the treatment of mycotic keratitis caused by molds [47].
However, for systemic treatment, the pharmacokinetic variability of the selected antifungal must be considered [48]. Amphotericin B has poor ocular penetration after intravenous (IV) administration and is known to cause severe renal toxicity [33, 49]. Penetration of itraconazole into the eyes is typically insufficient [50]. In contrast, the newer triazoles voriconazole and posaconazole are highly bioavailable and demonstrate good penetration into different parts of the eye [33].
In conclusion, our data contribute to a better understanding of the activity of antifungals used for treatment of disease caused by non-fumigatus Aspergillus species. Given the limited clinical evidence to support the treatment of non-fumigatus Aspergillus species, antifungal susceptibility testing may help to guide therapy, if performed in a timely manner. The colorimetric microbroth growth assay may also provide basic information on the individual effect of static concentrations of each antifungal on these fungi. A major limitation of the present study was the relatively low number of strains studied. Clearly, a wider range of isolates should be studied before any generalizations can be made. In addition, further dynamic in vivo modeling and clinical studies are required to investigate the correlation between in vitro susceptibility and in vivo clinical results.
References
Kalkanci A, Ozdek S. Ocular fungal infections. Curr Eye Res. 2011;36(3):179–89.
Lalitha P, Shapiro BL, Srinivasan M, et al. Antimicrobial susceptibility of Fusarium, Aspergillus, and other filamentous fungi isolated from keratitis. Arch Ophthalmol. 2007;125(6):789–93.
Schell WA, Foulks GN, Perfect JR. Fungal infections of the eye. In: Albert D, Miller J, Azar D, Blodi B, editors. Albert and Jakobiec’s principles and practice of opthalmology. Philadelphia: Saunders; 2008. p. 159–68.
Thomas PA. Current perspectives on ophthalmic mycoses. Clin Microbiol Rev. 2003;16(4):730–97.
Srinivasan M. Fungal keratitis. Curr Opin Ophthalmol. 2004;15(4):321–7.
Arora R, Gupta D, Goyal J, Kaur R. Voriconazole versus natamycin as primary treatment in fungal corneal ulcers. Clin Exp Ophthalmol. 2011;39(5):434–40.
Ramakrishnan T, Constantinou M, Jhanji V, Vajpayee RB. Factors affecting treatment outcomes with voriconazole in cases with fungal keratitis. Cornea. 2013;32(4):445–9.
Matsumoto Y, Murat D, Kojima T, Shimazaki J, Tsubota K. The comparison of solitary topical micafungin or fluconazole application in the treatment of Candida fungal keratitis. The British journal of ophthalmology. 2011;95(10):1406–9.
Saha S, Sengupta J, Banerjee D, Khetan A, Mandal SM. Schizophyllum commune: a new organism in eye infection. Mycopathologia. 2013;175(3–4):357–60.
Buchta V, Feuermannova A, Vasa M, et al. Outbreak of fungal endophthalmitis due to Fusarium oxysporum following cataract surgery. Mycopathologia. 2014;177(1–2):115–21.
Kredics L, Narendran V, Shobana CS, Vagvolgyi C, Manikandan P. Indo-Hungarian Fungal Keratitis Working G. Filamentous fungal infections of the cornea: a global overview of epidemiology and drug sensitivity. Mycoses. 2015;58(4):243–60.
Manikandan P, Varga J, Kocsube S, et al. Epidemiology of Aspergillus keratitis at a tertiary care eye hospital in South India and antifungal susceptibilities of the causative agents. Mycoses. 2013;56(1):26–33.
Baranyi N, Kocsube S, Szekeres A, et al. Keratitis caused by Aspergillus pseudotamarii. Med Mycol Case Rep. 2013;2:91–4.
Kredics L, Varga J, Kocsube S, et al. Case of keratitis caused by Aspergillus tamarii. J Clin Microbiol. 2007;45(10):3464–7.
Manikandan P, Varga J, Kocsube S, et al. Mycotic keratitis due to Aspergillus nomius. J Clin Microbiol. 2009;47(10):3382–5.
Kredics L, Varga J, Kocsube S, et al. Infectious keratitis caused by Aspergillus tubingensis. Cornea. 2009;28(8):951–4.
Manikandan P, Varga J, Kocsube S, et al. Keratitis caused by the recently described new species Aspergillus brasiliensis: two case reports. J Med Case Rep. 2010;4:68.
CLSI. Method for broth dilution antifungal susceptibility testing of conidium-forming filamentous fungi: approved standard M38-A2 (Eds). Wayne: Clinical and Laboratory Standards Institute; 2002
Kiraz N, Oz Y, Dag I. The evaluation of in vitro pharmacodynamic properties of amphotericin B, voriconazole and caspofungin against A. fumigatus isolates by the conventional and colorimetric time-kill assays. Med Mycol. 2011;49(6):594–601.
Mouton JW, Vinks AA. Pharmacokinetic/pharmacodynamic modelling of antibacterials in vitro and in vivo using bacterial growth and kill kinetics: the minimum inhibitory concentration versus stationary concentration. Clin Pharmacokinet. 2005;44(2):201–10.
Meletiadis J, Mouton JW, Meis JF, et al. Colorimetric assay for antifungal susceptibility testing of Aspergillus species. J Clin Microbiol. 2001;39(9):3402–8.
Ferro BE, van Ingen J, Wattenberg M, van Soolingen D, Mouton JW. Time-kill kinetics of antibiotics active against rapidly growing mycobacteria. J Antimicrob Chemother. 2015;70(3):811–7.
Van Der Linden JW, Warris A, Verweij PE. Aspergillus species intrinsically resistant to antifungal agents. Med Mycol. 2011;49(Suppl 1):S82–9.
Verweij PE, Howard SJ, Melchers WJ, Denning DW. Azole-resistance in Aspergillus: proposed nomenclature and breakpoints. Drug Resist Updat. 2009;12(6):141–7.
Verweij PE, Mellado E, Melchers WJ. Multiple-triazole-resistant aspergillosis. N Engl J Med. 2007;356(14):1481–3.
Gomez-Lopez A, Garcia-Effron G, Mellado E, Monzon A, Rodriguez-Tudela JL, Cuenca-Estrella M. In vitro activities of three licensed antifungal agents against Spanish clinical isolates of Aspergillus spp. Antimicrob Agents Chemother. 2003;47(10):3085–8.
van der Linden JW, Camps SM, Kampinga GA, et al. Aspergillosis due to voriconazole highly resistant Aspergillus fumigatus and recovery of genetically related resistant isolates from domiciles. Clin Infect Dis. 2013;57(4):513–20.
Varga J, Houbraken J, Der Van, Lee HA, Verweij PE, Samson RA. Aspergillus calidoustus sp. nov., causative agent of human infections previously assigned to Aspergillus ustus. Eukaryot Cell. 2008;7(4):630–8.
Lass-Florl C, Alastruey-Izquierdo A, Cuenca-Estrella M, Perkhofer S, Rodriguez-Tudela JL. In vitro activities of various antifungal drugs against Aspergillus terreus: global assessment using the methodology of the European committee on antimicrobial susceptibility testing. Antimicrob Agents Chemother. 2009;53(2):794–5.
Howard SJ, Harrison E, Bowyer P, Varga J, Denning DW. Cryptic species and azole resistance in the Aspergillus niger complex. Antimicrob Agents Chemother. 2011;55(10):4802–9.
Alcazar-Fuoli L, Mellado E, Alastruey-Izquierdo A, Cuenca-Estrella M, Rodriguez-Tudela JL. Species identification and antifungal susceptibility patterns of species belonging to Aspergillus section Nigri. Antimicrob Agents Chemother. 2009;53(10):4514–7.
Hariprasad SM, Mieler WF, Lin TK, Sponsel WE, Graybill JR. Voriconazole in the treatment of fungal eye infections: a review of current literature. Br J Ophthalmol. 2008;92(7):871–8.
Al-Badriyeh D, Neoh CF, Stewart K, Kong DC. Clinical utility of voriconazole eye drops in ophthalmic fungal keratitis. Clin Ophthalmol. 2010;4:391–405.
Altun A, Kurna SA, Sengor T et al. Effectiveness of posaconazole in recalcitrant fungal keratitis resistant to conventional antifungal drugs. Case Rep Ophthalmol Med. 2014. doi:10.1155/2014/701653.
Baddley JW, Marr KA, Andes DR, et al. Patterns of susceptibility of Aspergillus isolates recovered from patients enrolled in the Transplant-Associated Infection Surveillance Network. J Clin Microbiol. 2009;47(10):3271–5.
Alastruey-Izquierdo A, Cuesta I, Houbraken J, Cuenca-Estrella M, Monzon A, Rodriguez-Tudela JL. In vitro activity of nine antifungal agents against clinical isolates of Aspergillus calidoustus. Med Mycol. 2010;48(1):97–102.
Manavathu EK, Cutright JL, Loebenberg D, Chandrasekar PH. A comparative study of the in vitro susceptibilities of clinical and laboratory-selected resistant isolates of Aspergillus spp. to amphotericin B, itraconazole, voriconazole and posaconazole (SCH 56592). J Antimicrob Chemother. 2000;46(2):229–34.
Lewis RE, Albert ND, Kontoyiannis DP. Comparison of the dose-dependent activity and paradoxical effect of caspofungin and micafungin in a neutropenic murine model of invasive pulmonary aspergillosis. J Antimicrob Chemother. 2008;61(5):1140–4.
Pfaller MA, Messer SA, Woosley LN, Jones RN, Castanheira M. Echinocandin and triazole antifungal susceptibility profiles for clinical opportunistic yeast and mold isolates collected from 2010 to 2011: application of new CLSI clinical breakpoints and epidemiological cutoff values for characterization of geographic and temporal trends of antifungal resistance. J Clin Microbiol. 2013;51(8):2571–81.
Pfaller MA, Messer SA, Rhomberg PR, Jones RN, Castanheira M. In vitro activities of isavuconazole and comparator antifungal agents tested against a global collection of opportunistic yeasts and molds. J Clin Microbiol. 2013;51(8):2608–16.
Pfaller MA, Castanheira M, Messer SA, Moet GJ, Jones RN. Echinocandin and triazole antifungal susceptibility profiles for Candida spp., Cryptococcus neoformans, and Aspergillus fumigatus: application of new CLSI clinical breakpoints and epidemiologic cutoff values to characterize resistance in the SENTRY Antimicrobial Surveillance Program (2009). Diagn Microbiol Infect Dis. 2011;69(1):45–50.
Shivaprakash MR, Geertsen E, Chakrabarti A, Mouton JW, Meis JF. In vitro susceptibility of 188 clinical and environmental isolates of Aspergillus flavus for the new triazole isavuconazole and seven other antifungal drugs. Mycoses. 2011;54(5):e583–9.
Lockhart SR, Zimbeck AJ, Baddley JW, et al. In vitro echinocandin susceptibility of Aspergillus isolates from patients enrolled in the Transplant-Associated Infection Surveillance Network. Antimicrob Agents Chemother. 2011;55(8):3944–6.
Lalitha P, Sun CQ, Prajna NV, et al. In vitro susceptibility of filamentous fungal isolates from a corneal ulcer clinical trial. Am J Ophthalmol. 2014;157(2):318–26.
Thomas PA, Kaliamurthy J. Mycotic keratitis: epidemiology, diagnosis and management. Clin Microbiol Infect. 2013;19(3):210–20.
O’Brien TP. Therapy of ocular fungal infections. Ophthalmol Clin North Am. 1999;12(1):33–50.
Müller GG, Kara-José N, de Castro RS. Antifungals in eye infections: drugs and routes of administration. Rev Bras Oftalmol. 2013;72(2):132–41.
Kaur IP, Rana C, Singh H. Development of effective ocular preparations of antifungal agents. J Ocul Pharmacol Ther. 2008;24(5):481–93.
Khoo SH, Bond J, Denning DW. Administering amphotericin B—a practical approach. J Antimicrob Chemother. 1994;33(2):203–13.
Savani DV, Perfect JR, Cobo LM, Durack DT. Penetration of new azole compounds into the eye and efficacy in experimental Candida endophthalmitis. Antimicrob Agents Chemother. 1987;31(1):6–10.
Acknowledgments
Ocular Aspergillus isolates were provided by Dr. Havva Gül Özdemir from the CBS-KNAW Fungal Biodiversity Centre, Utrecht, the Netherlands.
Author information
Authors and Affiliations
Corresponding author
Ethics declarations
Conflict of interest
Seyedmojtaba Seyedmousavi has received research and travel grants from Astellas Pharma B.V. and travel grant from Gilead Sciences. All of the other authors have no competing interests. The authors alone are responsible for the content and composition of the manuscript.
Rights and permissions
Open Access This article is distributed under the terms of the Creative Commons Attribution 4.0 International License (http://creativecommons.org/licenses/by/4.0/), which permits unrestricted use, distribution, and reproduction in any medium, provided you give appropriate credit to the original author(s) and the source, provide a link to the Creative Commons license, and indicate if changes were made.
About this article
Cite this article
Öz, Y., Özdemir, H.G., Gökbolat, E. et al. Time-Kill Kinetics and In Vitro Antifungal Susceptibility of Non-fumigatus Aspergillus Species Isolated from Patients with Ocular Mycoses. Mycopathologia 181, 225–233 (2016). https://doi.org/10.1007/s11046-015-9969-z
Received:
Accepted:
Published:
Issue Date:
DOI: https://doi.org/10.1007/s11046-015-9969-z